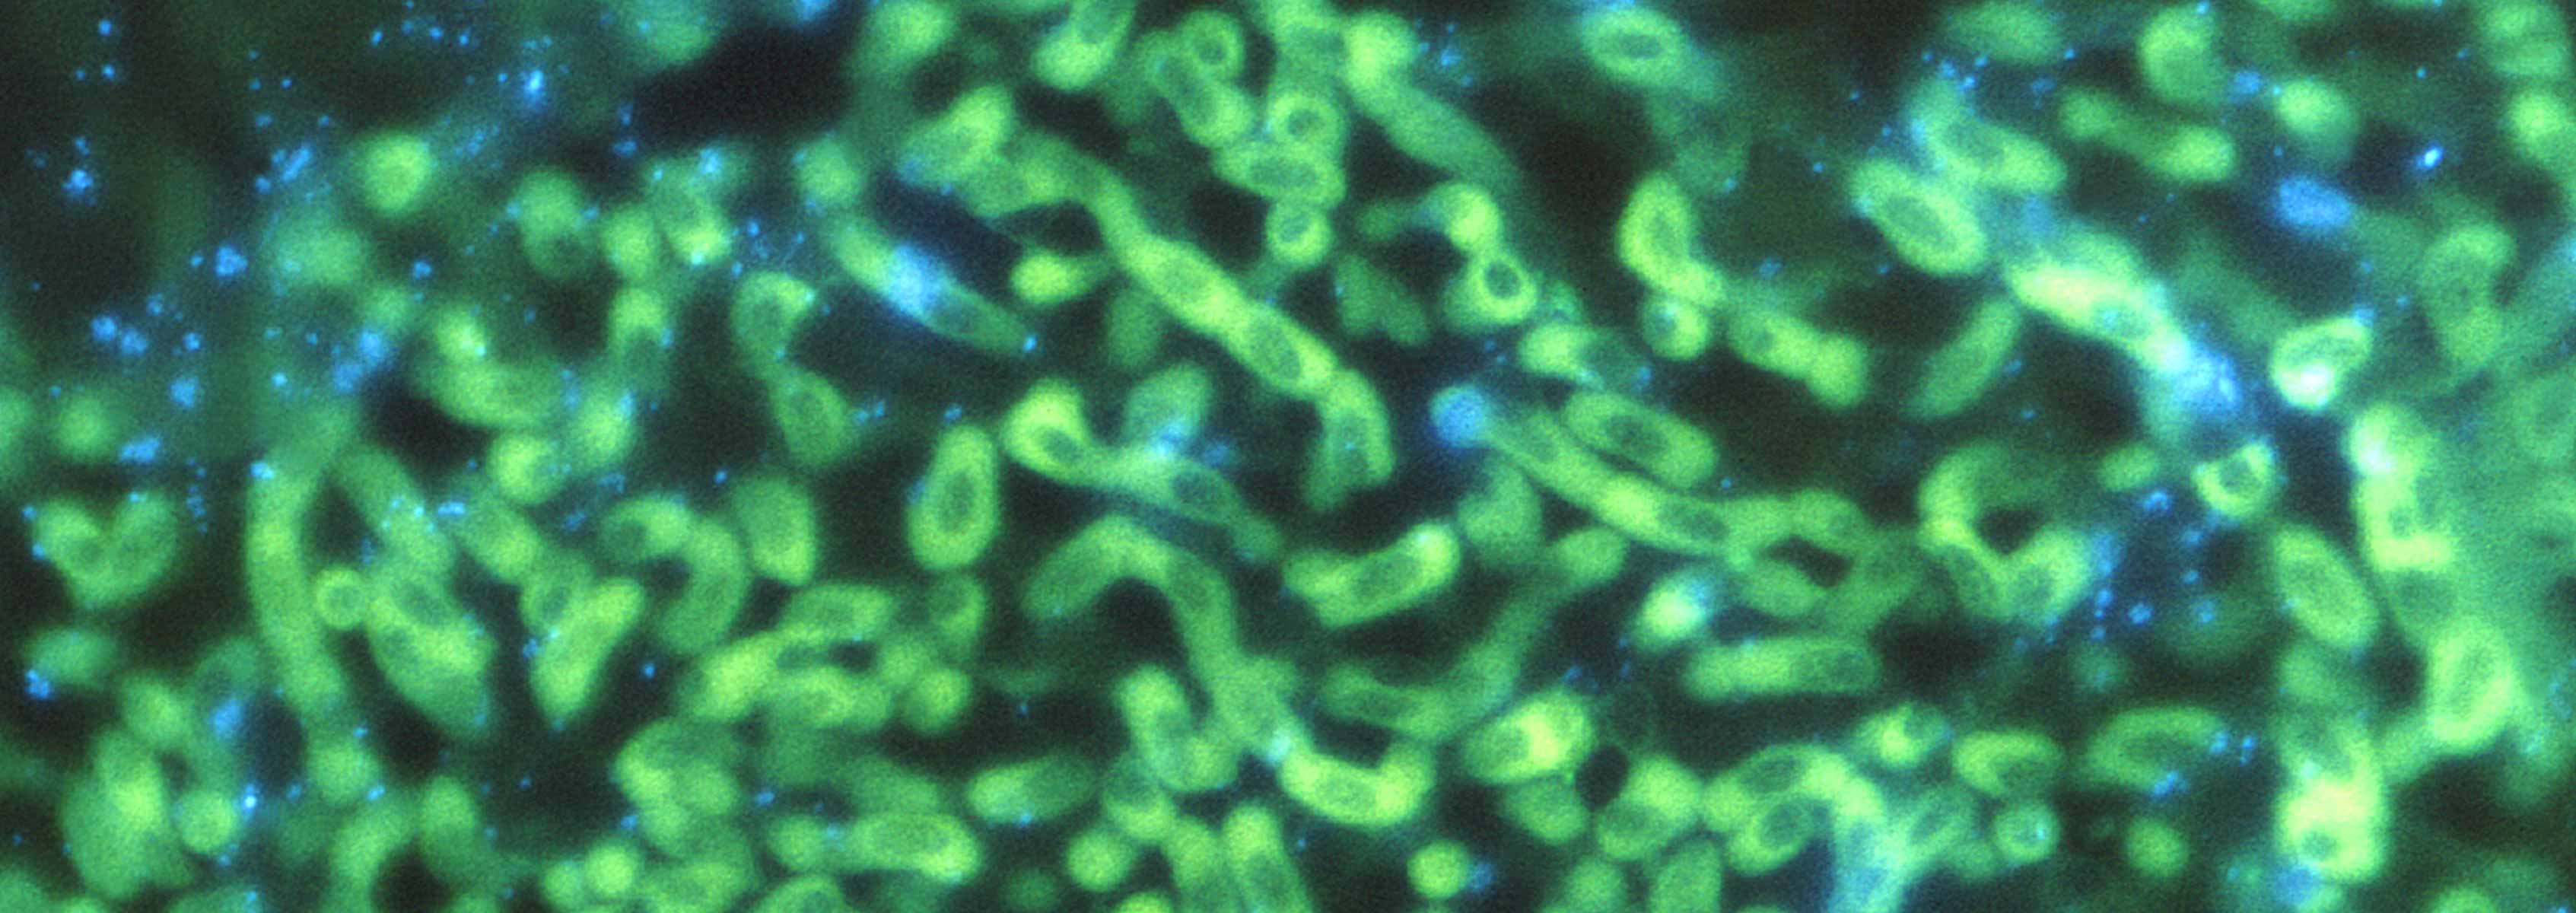

Host Pathogen Interactions in Invasive <em>Aspergillosis</em>
Aspergillus species are the most common cause of fungal respiratory infections in immunocompromised individuals. Aspergillus lung disease is determined by the interaction between the fungus and the host. Invasive aspergillosis (IA), the most serious form of aspergillosis, develops in severely immunocompromised patients, who might be undergoing . A compromised immune system may result from any of several circumstances including cancer chemotherapy, post lung transplant immunosuppression to manage graft vs. host disease, critically ill patients, and patients on steroidscancer treatments and organ transplants, and other immunosuppressive therapies. The rate of mortality with IA is 30-95%. Aspergillus fumigatus, a and Aspergillus flavus, ubiquitous environmental filamentous fungusi, are is the two most common pathogens causingcausative agent of aspergillosis. Despite the accumulating evidence of the medical significance of these common molds, our understanding of its pathogenic mechanisms is limited.
Although exposure of theseA. fumigatus spores through inhalation is common, very few of those exposed will develop respiratory tract disease. A. flavus is also of interest due to its acting as a pathogen of agricultural crops such as corn, and the fact that it can cause aflatoxin contamination of stored agriculture harvests of peanuts and corn. Asexual spores of both of these species are very common in the soil and in human habitation environments. Although exposure of these spores through inhalation is common, very few of those exposed will develop respiratory tract disease.
The rate of mortality with IA is 30-95%. Despite the accumulating evidence of the medical significance of these common molds, our understanding of its pathogenic mechanisms is limited. Epidemiological evidence studies demonstrates that concurrent host- and pathogen- mediated events govern the outcome of an A. fumigatus encounter. Accumulated evidence supports the critical role of alveolar macrophage and neutrophils as the essential components of the innate immune system in preventing the establishment of an invasive infection in immunoe competent mammalian hosts. This host-pathogen interaction paradigm necessitates the integrated study of both systems to understand the molecular basis of invasive aspergillus disease. We have amassed the molecular, cellular, and bioinformatic tools required to mount a systematic analysis of the A. fumigatus host-pathogen interaction with the aim of chronicling crucial landmarks of disease initiation and progression. Our key hypothesis is that mechanisms employed by A. fumigatus in overcoming the defenses of the immunoe compromisedsuppressed human host involve adapting the fungal metabolic pathways to iron depletion, alkaline shift, and nitrogen starvation as well as yet unknown lineage-specific pathways. Importantly, given the multifactorial nature of this these interactions and the heterogeneity of the susceptible patient population, we are performing a parallel study of both the intact mammalian mouse model systems and ex vivo immune cell-fungal interactions to decipher stage-specific molecular landmarks of infection.
To characterize the A. fumigatus host-pathogen interaction, we are using two approaches: in vitro macrophage and neutrophil infections of human cell lines; and mRNA expression profiles of infecting A. fumigatus- conidia and germlings and infected host cells in culture. This project is yielding a wealth of information on the host-pathogen interactions necessary for A. fumigatus to mount a successful invasive infection as well as host immune system components necessary to maintain protective immunity against the invading fungus. The data generated will direct therapeutic approaches to treating, and diagnosing these invasive infections. The host response analysis will identify approaches to modulate or augment the prophylactic or therapeutic regimens applied concurrently with organ transplant, neutropenia-inducing cancer chemotherapy, and other medical interventions in order to minimize the risk of invasive aspergillosis during and after these treatments.
Another common Aspergillus species that cause aspergillosis is Aspergillus flavus. A. flavus is also of interest due to its acting as a pathogen of agricultural crops such as corn, and the fact that it can cause aflatoxin contamination of stored agriculture harvests of peanuts and corn. Many of our studies of A. flavus concern the production of aflatoxin by the fungus. These studies have been conducted in collaboration with the USDA Southern Regional Research Center in New Orleans.
In a our collaborative studiesy with Dr. Jeffrey Cary from USDA, we performed maize infection studies using the plant pathogen Aspergillus flavus to determine the effect of A. flavus on resistant and susceptible maize strains. A. flavus-maize infections were performed at USDA, and samples were collected in a time course manner. Samples were processed at JCVI, and RNAseq experiments were performed to determine the fungal and maize transcripts that change significantly during infection. Using comparative analysis, we will determine whether resistant or susceptible maize strains respond to A. flavus differently at molecular level.
Publications
Funding
Funding for this project provided through the National Institutes of Health, National Institute of Allergy and Infectious Diseases (NIAID).